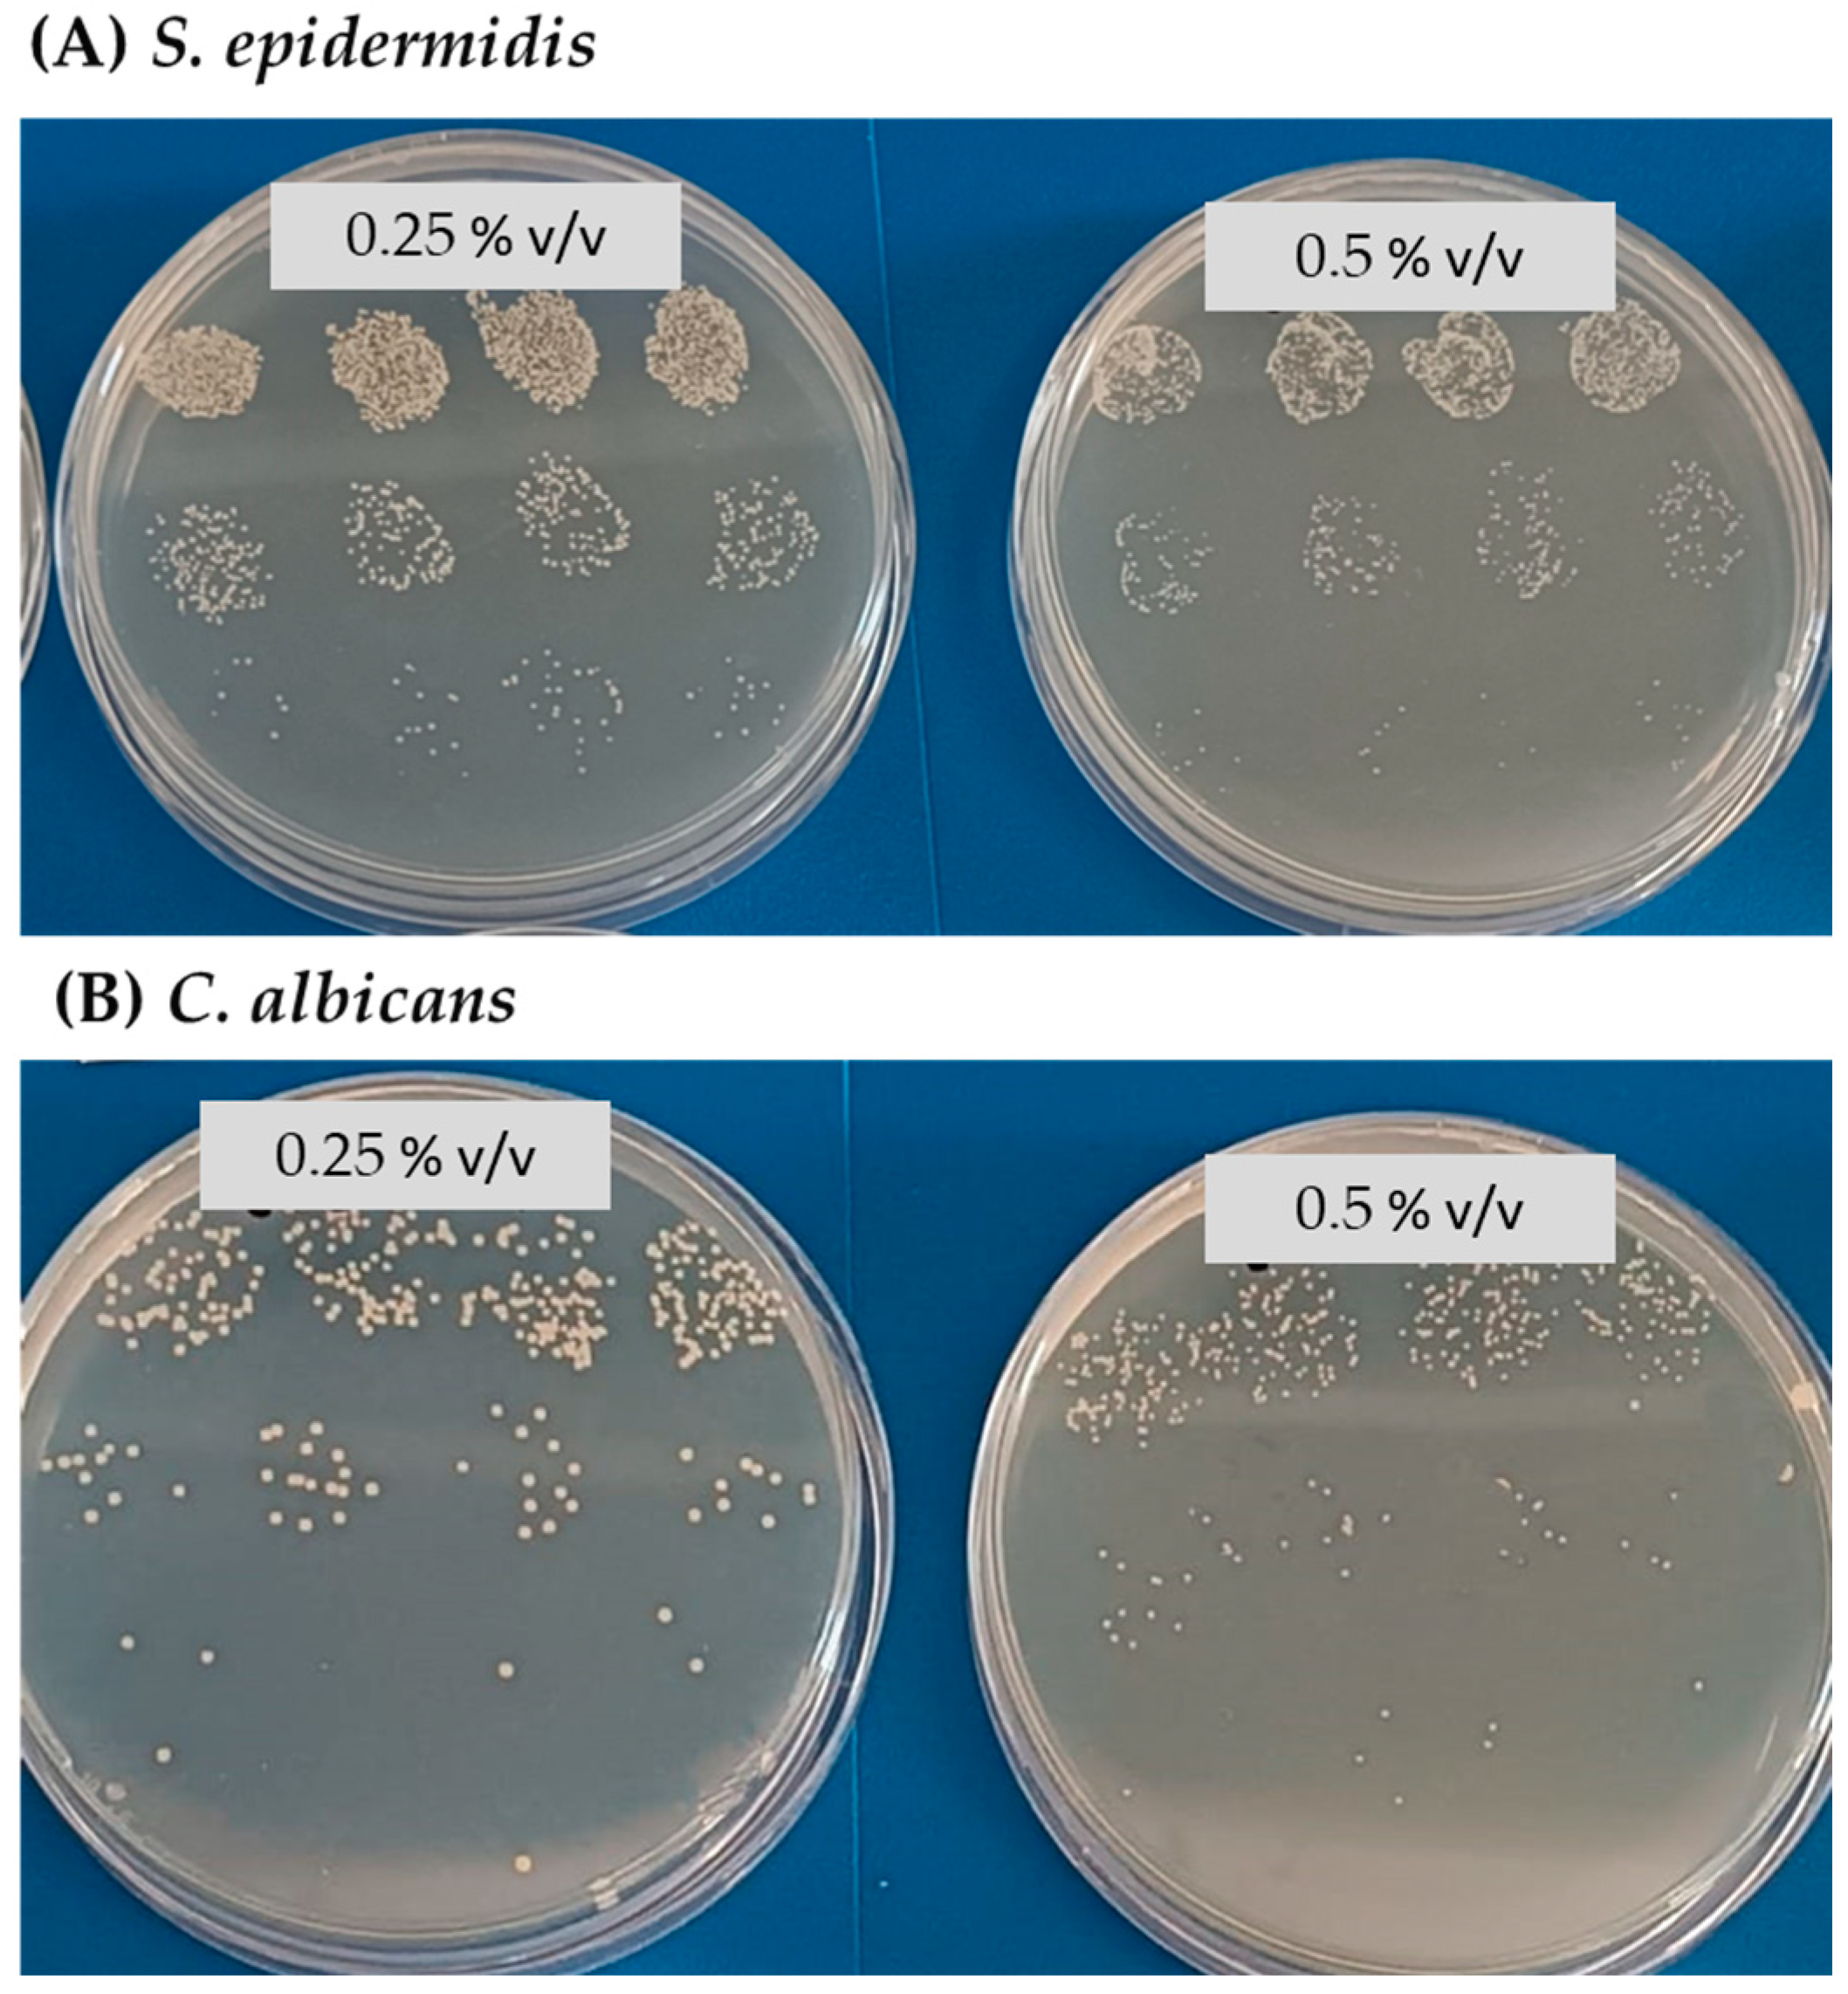

Antibacterial Activity Assessment of Chitosan/Alginate Lavender Essential Oil Membranes for Biomedical Applications
Abstract
1. Introduction
2. Materials and Methods
2.1. Preparation of Membranes
2.1.1. Materials
2.1.2. Membranes Synthesis Procedure
2.1.3. Sterilization of Membranes
2.2. Antimicrobial Capacity Analysis
2.2.1. Strains and Culture Media
2.2.2. Inoculum Solutions
2.2.3. Determination of Bactericidal Effect of LEO
2.2.4. Microbiological Study of Direct-Contact Membranes in Solid Media
2.2.5. Microbiological Study of Membranes in Broth
2.2.6. Database and Statistical Analysis
3. Results
3.1. Bactericidal Effect of LEO
3.2. Growth Inhibition Depending on the Time between Inoculum Addition and Culture
3.3. Bacterial Growth Resulting from Membranes Cultured Directly on Plates
3.4. Bacterial Growth Resulting from Membranes Cultured in Broth
4. Discussion
5. Conclusions
Author Contributions
Funding
Institutional Review Board Statement
Data Availability Statement
Acknowledgments
Conflicts of Interest
References
- Maddheshiya, S.; Ahmad, A.; Ahmad, W.; Zakir, F.; Aggarwal, G. Essential oils for the treatment of skin anomalies: Scope and potential. S. Afr. J. Bot. 2022, 151, 187–197. [Google Scholar] [CrossRef]
- Chen, Y.E.; Fischbach, M.A.; Belkaid, Y. Skin microbiota–host interactions. Nature 2018, 553, 427–436. [Google Scholar] [CrossRef] [PubMed]
- Vuong, C.; Otto, M. Staphylococcus epidermidis infections. Microbes Infect. 2002, 4, 481–489. [Google Scholar] [CrossRef] [PubMed]
- Tong, S.Y.C.; Davis, J.S.; Eichenberger, E.; Holland, T.L.; Fowler, V.G.J. Staphylococcus aureus infections: Epidemiology, pathophysiology, clinical manifestations, and management. Clin. Microbiol. Rev. 2015, 28, 603–661. [Google Scholar] [CrossRef] [PubMed]
- Gimeno Cardona, C. “Microbiología Clínica” de Guillem Prats. Enferm. Infecc. Microbiol. Clin. 2006, 24, 215. [Google Scholar] [CrossRef]
- Salerian, A.J. Burn wound infections and Pseudomonas aeruginosa. Burns 2020, 46, 257–258. [Google Scholar] [CrossRef] [PubMed]
- Nagoba, B.; Davane, M.; Gandhi, R.; Wadher, B.; Suryawanshi, N.; Selkar, S. Treatment of skin and soft tissue infections caused by Pseudomonas aeruginosa—A review of our experiences with citric acid over the past 20 years. Wound Med. 2017, 19, 5–9. [Google Scholar] [CrossRef]
- Nobile, C.J.; Johnson, A.D. Candida albicans Biofilms and Human Disease. Annu. Rev. Microbiol. 2015, 69, 71–92. [Google Scholar] [CrossRef]
- Lu, H.; Hong, T.; Jiang, Y.; Whiteway, M.; Zhang, S. Candidiasis: From cutaneous to systemic, new perspectives of potential targets and therapeutic strategies. Adv. Drug Deliv. Rev. 2023, 199, 114960. [Google Scholar] [CrossRef]
- Mohd Zaid, N.A.; Sekar, M.; Bonam, S.R.; Gan, S.H.; Lum, P.T.; Begum, M.Y.; Mat Rani, N.N.I.; Vaijanathappa, J.; Wu, Y.S.; Subramaniyan, V.; et al. Promising Natural Products in New Drug Design, Development, and Therapy for Skin Disorders: An Overview of Scientific Evidence and Understanding Their Mechanism of Action. Drug Des. Devel. Ther. 2022, 16, 23–66. [Google Scholar] [CrossRef]
- Djilani, A.; Dicko, A. The therapeutic benefits of essential oils. Nutr. Well-Being Health 2012, 7, 155–179. [Google Scholar]
- But, V.M.; Bulboacă, A.E.; Rus, V.; Ilyés, T.; Gherman, M.L.; Bolboacă, S.D. Anti-inflammatory and antioxidant efficacy of lavender oil in experimentally induced thrombosis. Thromb. J. 2023, 21, 85. [Google Scholar] [CrossRef] [PubMed]
- Chen, W.N.; Chin, K.W.; Tang, K.S.; Agatonovic-Kustrin, S.; Yeong, K.Y. Neuroprotective, neurite enhancing, and cholinesterase inhibitory effects of Lamiaceae family essential oils in Alzheimer’s disease model. J. Herb. Med. 2023, 41, 100696. [Google Scholar] [CrossRef]
- de Melo Alves Silva, L.C.; de Oliveira Mendes, F.d.C.; de Castro Teixeira, F.; de Lima Fernandes, T.E.; Barros Ribeiro, K.R.; da Silva Leal, K.C.; Dantas, D.V.; Neves Dantas, R.A. Use of Lavandula angustifolia essential oil as a complementary therapy in adult health care: A scoping review. Heliyon 2023, 9, e15446. [Google Scholar] [CrossRef]
- Rivaz, M.; Rahpeima, M.; Khademian, Z.; Dabbaghmanesh, M.H. The effects of aromatherapy massage with lavender essential oil on neuropathic pain and quality of life in diabetic patients: A randomized clinical trial. Complement. Ther. Clin. Pract. 2021, 44, 101430. [Google Scholar] [CrossRef]
- Sofi, H.S.; Akram, T.; Tamboli, A.H.; Majeed, A.; Shabir, N.; Sheikh, F.A. Novel lavender oil and silver nanoparticles simultaneously loaded onto polyurethane nanofibers for wound-healing applications. Int. J. Pharm. 2019, 569, 118590. [Google Scholar] [CrossRef]
- Liakos, I.; Rizzello, L.; Scurr, D.J.; Pompa, P.P.; Bayer, I.S.; Athanassiou, A. All-natural composite wound dressing films of essential oils encapsulated in sodium alginate with antimicrobial properties. Int. J. Pharm. 2014, 463, 137–145. [Google Scholar] [CrossRef]
- Singh, N.K.; Baranwal, J.; Pati, S.; Barse, B.; Khan, R.H.; Kumar, A. Application of plant products in the synthesis and functionalisation of biopolymers. Int. J. Biol. Macromol. 2023, 237, 124174. [Google Scholar] [CrossRef]
- Syed, M.H.; Zahari, M.A.K.M.; Khan, M.M.R.; Beg, M.D.H.; Abdullah, N. An overview on recent biomedical applications of biopolymers: Their role in drug delivery systems and comparison of major systems. J. Drug Deliv. Sci. Technol. 2023, 80, 104121. [Google Scholar] [CrossRef]
- Ren, W.; Cheng, W.; Wang, G.; Liu, Y. Developments in antimicrobial polymers. J. Polym. Sci. Part A Polym. Chem. 2017, 55, 632–639. [Google Scholar] [CrossRef]
- López-Mata, M.A.; Ruiz-Cruz, S.; de Jesús Ornelas-Paz, J.; Del Toro-Sánchez, C.L.; Márquez-Ríos, E.; Silva-Beltrán, N.P.; Cira-Chávez, L.A.; Burruel-Ibarra, S.E. Mechanical, Barrier and Antioxidant Properties of Chitosan Films Incorporating Cinnamaldehyde. J. Polym. Environ. 2018, 26, 452–461. [Google Scholar] [CrossRef]
- Bano, I.; Arshad, M.; Yasin, T.; Ghauri, M.A.; Younus, M. Chitosan: A potential biopolymer for wound management. Int. J. Biol. Macromol. 2017, 102, 380–383. [Google Scholar] [CrossRef]
- Zhou, H.; Yang, N.; Hou, J.; Yu, C.; Jin, Z.; Zeng, P.; Yang, L.; Fu, Y.; Shen, Y.; Guo, S. Effects of CaCl2, HCl, acetic acid or citric acid on dynamic mechanical performances and physicochemical properties of sodium alginate edible films. Food Packag. Shelf Life 2022, 34, 100935. [Google Scholar] [CrossRef]
- Baysal, K.; Aroguz, A.Z.; Adiguzel, Z.; Baysal, B.M. Chitosan/alginate crosslinked hydrogels: Preparation, characterization and application for cell growth purposes. Int. J. Biol. Macromol. 2013, 59, 342–348. [Google Scholar] [CrossRef] [PubMed]
- Rodrigues, A.P.; Sanchez, E.M.S.; Da Costa, A.C.; Moraes, A.M. The influence of preparation conditions on the characteristics of chitosan-alginate dressings for skin lesions. J. Appl. Polym. Sci. 2008, 109, 2703–2710. [Google Scholar] [CrossRef]
- Caetano, G.F.; Frade, M.A.C.; Andrade, T.A.M.; Leite, M.N.; Bueno, C.Z.; Moraes, Â.M.; Ribeiro-Paes, J.T. Chitosan-alginate membranes accelerate wound healing. J. Biomed. Mater. Res. Part B Appl. Biomater. 2015, 103, 1013–1022. [Google Scholar] [CrossRef] [PubMed]
- Feketshane, Z.; Adeyemi, S.A.; Ubanako, P.; Ndinteh, D.T.; Ray, S.S.; Choonara, Y.E.; Aderibigbe, B.A. Dissolvable sodium alginate-based antibacterial wound dressing patches: Design, characterization, and in vitro biological studies. Int. J. Biol. Macromol. 2023, 232, 123460. [Google Scholar] [CrossRef]
- Istiqomah, A.; Utami, M.R.; Firdaus, M.; Suryanti, V.; Kusumaningsih, T. Antibacterial chitosan-Dioscorea alata starch film enriched with essential oils optimally prepared by following response surface methodology. Food Biosci. 2022, 46, 101603. [Google Scholar] [CrossRef]
- Benavides, S.; Villalobos-Carvajal, R.; Reyes, J.E. Physical, mechanical and antibacterial properties of alginate film: Effect of the crosslinking degree and oregano essential oil concentration. J. Food Eng. 2012, 110, 232–239. [Google Scholar] [CrossRef]
- Frank, K.; Garcia, C.V.; Shin, G.H.; Kim, J.T. Alginate Biocomposite Films Incorporated with Cinnamon Essential Oil Nanoemulsions: Physical, Mechanical, and Antibacterial Properties. Int. J. Polym. Sci. 2018, 2018, 1519407. [Google Scholar] [CrossRef]
- Pereira Dos Santos, E.; Nicácio, P.H.M.; Coêlho Barbosa, F.; Nunes da Silva, H.; Andrade, A.L.S.; Lia Fook, M.V.; de Lima Silva, S.M.; Farias Leite, I. Chitosan/Essential Oils Formulations for Potential Use as Wound Dressing: Physical and Antimicrobial Properties. Materials 2019, 12, 2223. [Google Scholar] [CrossRef] [PubMed]
- Wei, Z.; Huang, L.; Feng, X.; Cui, F.; Wu, R.; Kong, Q.; Sun, K.; Gao, J.; Guo, J. Development of functional, sustainable pullulan-sodium alginate-based films by incorporating essential oil microemulsion for chilled pork preservation. Int. J. Biol. Macromol. 2023, 253, 127257. [Google Scholar] [CrossRef] [PubMed]
- Cruz Sánchez, E.; García, M.T.; Pereira, J.; Oliveira, F.; Craveiro, R.; Paiva, A.; Gracia, I.; García-Vargas, J.M.; Duarte, A.R.C. Alginate-Chitosan Membranes for the Encapsulation of Lavender Essential Oil and Development of Biomedical Applications Related to Wound Healing. Molecules 2023, 28, 3689. [Google Scholar] [CrossRef] [PubMed]
- Serra, R.; Grande, R.; Butrico, L.; Rossi, A.; Settimio, U.F.; Caroleo, B.; Amato, B.; Gallelli, L.; de Franciscis, S. Chronic wound infections: The role of Pseudomonas aeruginosa and Staphylococcus aureus. Expert Rev. Anti-Infect. Ther. 2015, 13, 605–613. [Google Scholar] [CrossRef] [PubMed]
- Wilson, A.P.R.; Grüneberg, R.N.; Treasure, T.; Sturridge, M.F. Staphylococcus epidermidis as a cause of postoperative wound infection after cardiac surgery: Assessment of pathogenicity by a wound-scoring method. Br. J. Surg. 2005, 75, 168–170. [Google Scholar] [CrossRef] [PubMed]
- Gutiérrez-Jara, C.; Bilbao-Sainz, C.; McHugh, T.; Chiou, B.; Williams, T.; Villalobos-Carvajal, R. Physical, mechanical and transport properties of emulsified films based on alginate with soybean oil: Effects of soybean oil concentration, number of passes and degree of surface crosslinking. Food Hydrocoll. 2020, 109, 106133. [Google Scholar] [CrossRef]
- Gismondi, A.; Di Marco, G.; Redi, E.L.; Ferrucci, L.; Cantonetti, M.; Canini, A. The antimicrobial activity of Lavandula angustifolia Mill. essential oil against Staphylococcus species in a hospital environment. J. Herb. Med. 2021, 26, 100426. [Google Scholar] [CrossRef]
- Dănilă, E.; Moldovan, Z.; Popa, M.; Chifiriuc, M.C.; Kaya, A.D.; Kaya, M.A. Chemical composition, antimicrobial and antibiofilm efficacy of C. limon and L. angustifolia EOs and of their mixtures against Staphylococcus epidermidis clinical strains. Ind. Crops Prod. 2018, 122, 483–492. [Google Scholar] [CrossRef]
- Dhifi, W.; Bellili, S.; Jazi, S.; Bahloul, N.; Mnif, W. Essential Oils’ Chemical Characterization and Investigation of Some Biological Activities: A Critical Review. Medicines 2016, 3, 25. [Google Scholar] [CrossRef]
- Cutro, A.C.; Coria, M.S.; Bordon, A.; Rodriguez, S.A.; Hollmann, A. Antimicrobial properties of the essential oil of Schinus areira (Aguaribay) against planktonic cells and biofilms of S. aureus. Arch. Biochem. Biophys. 2023, 744, 109670. [Google Scholar] [CrossRef]
- Liu, J.; Liu, Y.; Shao, S.; Zheng, X.; Tang, K. Soluble soybean polysaccharide/carboxymethyl chitosan coatings incorporated with lavender essential oil: Structure, properties and application in fruit preservation. Prog. Org. Coat. 2022, 173, 107178. [Google Scholar] [CrossRef]
- Liao, S.; Yang, G.; Ou, Y.; Huang, S.; Li, B.; Li, A.; Kan, J. Inhibitory impacts of essential oil (Zanthoxylum schinifolium Sieb. et Zucc) on the growth of Staphylococcus epidermidis. Food Biosci. 2022, 49, 101906. [Google Scholar] [CrossRef]
- Cavanagh, H.M.A.; Wilkinson, J.M. Lavender essential oil: A review. Aust. Infect. Control 2005, 10, 35–37. [Google Scholar] [CrossRef]
- Danila, A.; Muresan, E.I.; Ibanescu, S.-A.; Popescu, A.; Danu, M.; Zaharia, C.; Türkoğlu, G.C.; Erkan, G.; Staras, A.-I. Preparation, characterization, and application of polysaccharide-based emulsions incorporated with lavender essential oil for skin-friendly cellulosic support. Int. J. Biol. Macromol. 2021, 191, 405–413. [Google Scholar] [CrossRef] [PubMed]
- Alavi, M.; Nokhodchi, A. An overview on antimicrobial and wound healing properties of ZnO nanobiofilms, hydrogels, and bionanocomposites based on cellulose, chitosan, and alginate polymers. Carbohydr. Polym. 2020, 227, 115349. [Google Scholar] [CrossRef]
- Sukhodub, L.; Kumeda, M.; Sukhodub, L.; Bielai, V.; Lyndin, M. Metal ions doping effect on the physicochemical, antimicrobial, and wound healing profiles of alginate-based composite. Carbohydr. Polym. 2023, 304, 120486. [Google Scholar] [CrossRef]
- Aditya Wardana, A.; Tanaka, F.; Tanaka, F. Inhibition of Botrytis cinerea by alginate/cajuput essential oil and the composite’s surface properties as potential antifungal coating. Mater. Today Proc. 2021, 45, 5263–5268. [Google Scholar] [CrossRef]
- Choi, Y.; Jang, J.; Koo, H.-J.; Tanaka, M.; Lee, K.-H.; Choi, J. Alginate-chitosan Hydrogel Patch with Beta-glucan Nanoemulsion for Antibacterial Applications. Biotechnol. Bioprocess Eng. 2021, 26, 71–77. [Google Scholar] [CrossRef]
- Costa-Fernandez, S.; Matos, J.K.R.; Scheunemann, G.S.; Salata, G.C.; Chorilli, M.; Watanabe, I.-S.; de Araujo, G.L.B.; Santos, M.F.; Ishida, K.; Lopes, L.B. Nanostructured lipid carriers containing chitosan or sodium alginate for co-encapsulation of antioxidants and an antimicrobial agent for potential application in wound healing. Int. J. Biol. Macromol. 2021, 183, 668–680. [Google Scholar] [CrossRef]
- Agarwal, V.; Lal, P.; Pruthi, V. Effect of plant oils on Candida albicans. J. Microbiol. Immunol. Infect. 2010, 43, 447–451. [Google Scholar] [CrossRef]
- Wichai, S.; Chuysinuan, P.; Chaiarwut, S.; Ekabutr, P.; Supaphol, P. Development of bacterial cellulose/alginate/chitosan composites incorporating copper (II) sulfate as an antibacterial wound dressing. J. Drug Deliv. Sci. Technol. 2019, 51, 662–671. [Google Scholar] [CrossRef]

| Bacterial Species | Source |
|---|---|
| Staphylococcus aureus | Strain isolated in 2017 from the nasal cavity of a human carrier, as part of its saprophytic microbiota. |
| Pseudomonas aeruginosa | Strain isolated in 2022 from a clinical case from the microbiology department of the Hospital General Universitario de Ciudad Real. |
| Candida albicans | Strain isolated in 2017 from a clinical case from the microbiology department of the Hospital General Universitario de Ciudad Real. |
| Staphylococcus epidermididis | Strain isolated in 2017 from skin microbiota of a human carrier, as part of its saprophytic microbiota. |
| Strain | Control | 0.1% v/v LEO | 0.25% v/v LEO | 0.5% v/v LEO | 0.75% v/v LEO | 1% v/v LEO |
|---|---|---|---|---|---|---|
| C. albicans | 1184 | 2090 | 1613 | 1488 | 0 | 0 |
| P. aeruginosa | 1850 | 2325 | 2300 | 3230 | 950 | 0 |
| S. aureus | 8150 | 7100 | 14000 | 11650 | 4350 | 0 |
| S. epidermidis | 1800 | 1775 | 1033 | 950 | 0 | 0 |
Disclaimer/Publisher’s Note: The statements, opinions and data contained in all publications are solely those of the individual author(s) and contributor(s) and not of MDPI and/or the editor(s). MDPI and/or the editor(s) disclaim responsibility for any injury to people or property resulting from any ideas, methods, instructions or products referred to in the content. |
© 2024 by the authors. Licensee MDPI, Basel, Switzerland. This article is an open access article distributed under the terms and conditions of the Creative Commons Attribution (CC BY) license (https://creativecommons.org/licenses/by/4.0/).
Share and Cite
Cruz Sánchez, E.; García, M.T.; Gracia, I.; Fernández-Bermejo, S.I.; Rodríguez, J.F.; García-Vargas, J.M.; Vidal Roig, D. Antibacterial Activity Assessment of Chitosan/Alginate Lavender Essential Oil Membranes for Biomedical Applications. Membranes 2024, 14, 12. https://doi.org/10.3390/membranes14010012
Cruz Sánchez E, García MT, Gracia I, Fernández-Bermejo SI, Rodríguez JF, García-Vargas JM, Vidal Roig D. Antibacterial Activity Assessment of Chitosan/Alginate Lavender Essential Oil Membranes for Biomedical Applications. Membranes. 2024; 14(1):12. https://doi.org/10.3390/membranes14010012
Chicago/Turabian StyleCruz Sánchez, Encarnación, María Teresa García, Ignacio Gracia, Soledad Illescas Fernández-Bermejo, Juan Francisco Rodríguez, Jesús Manuel García-Vargas, and Dolors Vidal Roig. 2024. "Antibacterial Activity Assessment of Chitosan/Alginate Lavender Essential Oil Membranes for Biomedical Applications" Membranes 14, no. 1: 12. https://doi.org/10.3390/membranes14010012
APA StyleCruz Sánchez, E., García, M. T., Gracia, I., Fernández-Bermejo, S. I., Rodríguez, J. F., García-Vargas, J. M., & Vidal Roig, D. (2024). Antibacterial Activity Assessment of Chitosan/Alginate Lavender Essential Oil Membranes for Biomedical Applications. Membranes, 14(1), 12. https://doi.org/10.3390/membranes14010012









